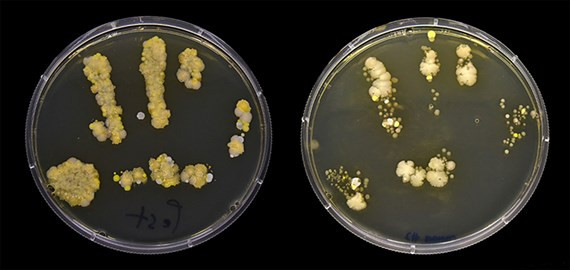

Theo ước tính của Trung tâm Kiểm soát và phòng ngừa bệnh tật Mỹ, đến 80% các ca nhiễm bệnh được truyền qua bàn tay.
![]() |
Tiến sĩ Chris Sham, Giáo sư Sinh học vi khuẩn tại Đại học Quốc gia Singapore, cho biết có 2 loại vi khuẩn trên bàn tay đó là vi khuẩn cư trú tay người và vi khuẩn thoáng qua. Vi khuẩn thoáng qua là những gì có trong quá trình chạm hoặc tương tác với người và vật xung quanh.
Vi khuẩn cư trú luôn có mặt trên da của chúng ta và thường là vô hại. Vì vậy, lời khuyên của các bác sĩ là luôn rửa tay sạch trước khi ăn và sau khi tiếp xúc với môi trường có nhiều vi khuẩn.
Gia Bảo (sggp)